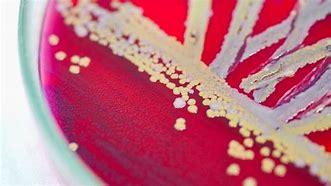
Natural Treatment Against Babesiose

Herbal Tea 530: Natural Treatment Against Babesiose
Natural Treatment Against Babesiosis. We offer you at a flat price an excellent tea to cure Babesiosis completely in a short time.
Click here to join us

Reference: t-530
In stock: 3000
30,00€ inc. tax
Natural Treatment Against Babesiosis How to cure Babesiosis? What plant is used to treat Babesiosis? How to Prevent Babesiosis? What is the main cause of Babesiosis?
Research Associated with Natural Treatment for Babesiosis
Natural Treatment Against Babesiosis, How to cure Babesiosis? What plant is used to treat Babesiosis?, How to Prevent Babesiosis?, What is the main cause of Babesiosis?
If you need advice write to us here
Definition of babesiosis
Babesiosis, also known as pyroplasmosis, is a parasitic disease that affects animals. In human medicine, it is extremely rare. In fact, this disease has a multitude of symptoms that may resemble other diseases, such as autoimmune diseases and certain neurological conditions. However, babesiosis and malaria can be distinguished because of their similar symptoms, such as fever and anemia. Therefore, it is often diagnosed too late, causing much damage to the body.
GET A RIDE WITH LADY FERANMI HERE
Causes of Babesiosis
Babesiosis, which is caused by a tick bite transmitted by a pathogen known as babesia. During a bite of this infected tick, the majority of patients contract an infection.
Humans can also contract the parasite through transfusions of blood or products derived from contaminated blood. It infects the red blood cells inside which it reproduces by a doubling which causes the release of parasites into the bloodstream, which causes hemolytic anemia.
People with reduced protective functions of the immune system are affected by babesiosis. Secondly, it affects the elderly, patients with serious illnesses who have altered their immune system and patients who have undergone splenectomy. Parasitic microorganisms usually appear in people with human immunodeficiency viruses.
Technical Sheet of the Natural Treatment Against Babesiosis
Presentation of the Natural Treatment Against Babesiosis
50g bag or pot powder
Composition of the Natural Solution Against Babesiosis
-Plant extracts (Cochlospermum, trichilia, argemone, caicedrate, AIDS acuta, Artemisia annua, Cryptolepis sanguineolenta)
Active ingredients Natural Treatment Against Babesiosis
Tannins, cinchona, natural artemisinin, etc.
Indication of Herbal Tea 530
Babesiosis, Malaria, Lyme
Price:
€30
GET A RIDE WITH LADY FERANMI HERE
The Beneficial Effects of the Natural Treatment Against Babesiosis
Thanks to its richness in active ingredients such as AIDS acuta and Artemisia annua, Tisane 530 offers an effective natural treatment against babesiosis. It contains antipyretic substances such as caicedrate and Kaya senegalensis. These fight against fever attacks associated with illness attacks. While the other components act on the parasite, which guarantees immediate relief and certain healing in a record time. The tea remains effective even in cases of cerebral malaria. The depurative and diuretic components facilitate the removal of parasites and toxins.